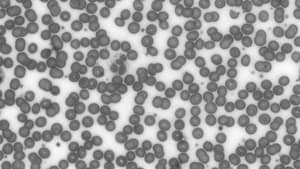
Grayscale Filter — After

Support
 Grayscale Filter
Grayscale Filter
Filter Manager
Information in this article applies to:
- uScope Navigator V4.5 and Later
Article ID: NFL1277 — Created: 21 Aug 2019 — Reviewed: 13 Dec 2020
Summary
 A Grayscale Filter has been added to uScope Navigator v4.5. This filter converts a color image to a 256-shades of gray.
A Grayscale Filter has been added to uScope Navigator v4.5. This filter converts a color image to a 256-shades of gray.
Controls are available to control the amounts of Red, Green, and Blue that comprise the grayscale image.
Details
The Grayscale Filter converts color images to grayscale images with 256 shades of gray using standard color mixing to generate a gray shade or each combination of red, green, and blue.

Grayscale Filter — Before
Grayscale Filter — After
 Controls let you select the amount of red, green, and blue to combine when creating grayscale pixels. A coefficient for each color is used in a standard formula for converting the sRGB color space defined in terms of the CIE 1931 luminance. The default coefficients are shown in the following formula:
Controls let you select the amount of red, green, and blue to combine when creating grayscale pixels. A coefficient for each color is used in a standard formula for converting the sRGB color space defined in terms of the CIE 1931 luminance. The default coefficients are shown in the following formula:
In general, these settings should be sufficient for most grayscale image conversions. However, you may set them to suit your requirements.
Note
The coefficients specified for the grayscale conversion should add to 1.00 (100%).
Setting Custom Coefficients
You may, of course, set the coefficients to suit your requirements. For example:
- You may wish to create a grayscale image using pixel information from only one color. To do so for Red, set the Red coefficient to 1.000 and Green and Blue to 0.000.
- To create the grayscale image using half of the Red pixel value and half of the Blue pixel value, set the Red and Blue coefficients to 0.500 and the Green coefficient to 0.000.
Related Articles
- What is Flat-Field Correction?
Filter Manager - Preview Overview Image when Creating a Filter
Filter Manager - Contrast Expand Process
Filter Manager